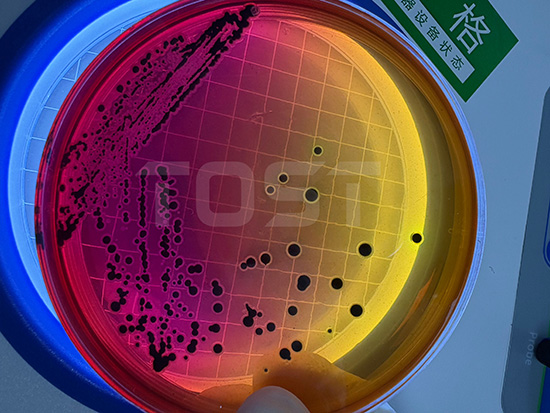
fd60e199cac6bbf2e333ef5bb498a523.jpg

天气一冷,火锅、麻辣烫这些暖身的美食就成了咱干饭人挂在嘴边的美食,那些热乎的牛肉丸、鲜美的鱼丸,一口下去心里忍不住在尖叫,真是太舒坦了。
但咱在吃的时候心里面会不会在嘀咕着:这丸子会不会不干净?添加剂是不是加了很多?一嘴下去该不会都是科技与狠活吧!

图片来源于千图网
别急!专业第三方检测机构来为您解答疑虑了,今天就化身“丸子侦探”,带大家一起扒一扒这些丸子的底细!

图片来源于网络
小编在买丸子时会习惯的先检查看看,然后拿起来仔细观察,捏一捏,再来决定要不要买,毕竟咱都是花了真金白银的,可不能当了冤大头了~
检测机构的检查会比咱检查的更加仔细,从多个方面来检测,有问题的经过检测员的手就显出原型了。
从外观看:好的丸子是圆润饱满的,不会有变形、开裂或凹陷等情况。如果在检测时发现丸子歪七扭八的,一捏就碎了,可能是制作时的工艺不到位,也可能是原料不新鲜,这样的就别犹豫了,直接Pass!

图片来源于千图网
从颜色看:不同丸子有不同的正常的颜色 —— 牛肉丸偏暗红色、鱼丸偏浅白色等。如果检测时看到丸子颜色奇怪的,发黑、发黄等,可能就会有问题。
组织与结构:好的丸子咬开后,不会有大颗粒的那种硬疙瘩,咬的时候也是紧实不松散的。检测员会切开丸子来仔细观察,来确保它的口感。

图片来源于千图网
从味道看:新鲜的丸子只有肉本身自带的香味,比如鱼丸带点海鲜味、牛肉丸带点肉香味。检测时闻到腥臭味,或者别的奇怪的味,表明丸子已经变质了,这是不能吃的!
从杂质看:这是 “干净度” 的检查。检测员会仔细查看丸子表面和内部,确保没有头发、塑料渣这些不该出现在丸子里的东西 —— 毕竟谁也不想吃的正开心的时候吃到“惊喜”吧。
有些问题光靠眼睛是看不出来里面有什么东西的,得靠专业设备来“抓鸡脚”,比如是否存在有害细菌、盐分是不是太高啦~~咱主要盯这几个 “安全指标”:
专业上称为大肠菌群的指标,说的大众一点,就是看丸子是不是被 “脏东西” 污染了。
就像是给食品做一次“粪便污染”的体检。
它的核心价值在于用简单的方法预警复杂的风险,是保障食品安全的第一道重要防线。

图片来源于千图网
大肠菌群主要来源于人及温血动物的肠道。
如果食品中检出大肠菌群,则意味着该食品直接或间接地受到了粪便的污染。
而许多可怕的肠道致病菌(如沙门氏菌、志贺氏菌、霍乱弧菌等)也来源于粪便。因此,检出大肠菌群预示着存在被这些致病菌污染的风险。
关键的是致病菌:重点检测 “单核细胞增生李斯特氏菌”(简称李斯特菌)和 “志贺氏菌”。
这两种都属于致病菌 —— 李斯特菌特别是对孕妇、老人和小孩等免疫力弱的群体伤害比较大,可能引起发热、上吐下泻等等;志贺氏菌会导致急性肠胃炎,严重时还会脱水。
只要检测出这两种细菌,丸子就属于 “不合格产品”,是不能进行售卖的。

图片来源于千图网
还有盐分(氯化物):很多丸子为了调味和防腐,会加不少的盐进去,氯化物就是测盐分的,检测时若发现氯化物含量太高,就说明丸子太咸,长期吃会增加身体的负担,尤其是要控盐的人群和高血压人群,这可不能多吃和贪吃哦。
有人不了解会觉得说,你们测这些,对咱普通人有啥用?
其实不管是消费者还是商家,都能从检测里获得好处的:
对消费者来说咱不用再靠“玄学”来判断丸子的品质,只要检测合格就可以放心炫啦!

图片来源于千图网
对商家来说,检测能证明自家产品的品质。无论是给顾客看,还是监管部门来检查,有了合格的检测报告,就能更加放心地售卖,也能让顾客更放心信任,这样才会多多回购嘛
安全小贴士
除了要看检测报告,平时自己也得多留意:要在正规场所购买,包装上要有生产日期、保质期和生产厂家等具体信息;

无论是消费者还是商家,想给丸子做 “安全体检”的,随时找我们哟~ 从外表到内在,我们把好每一道关卡,让大家健康又放心!
毕竟咱作为一名优秀的干饭人,总不能为了一口丸子,跟自己的健康过不去吧!